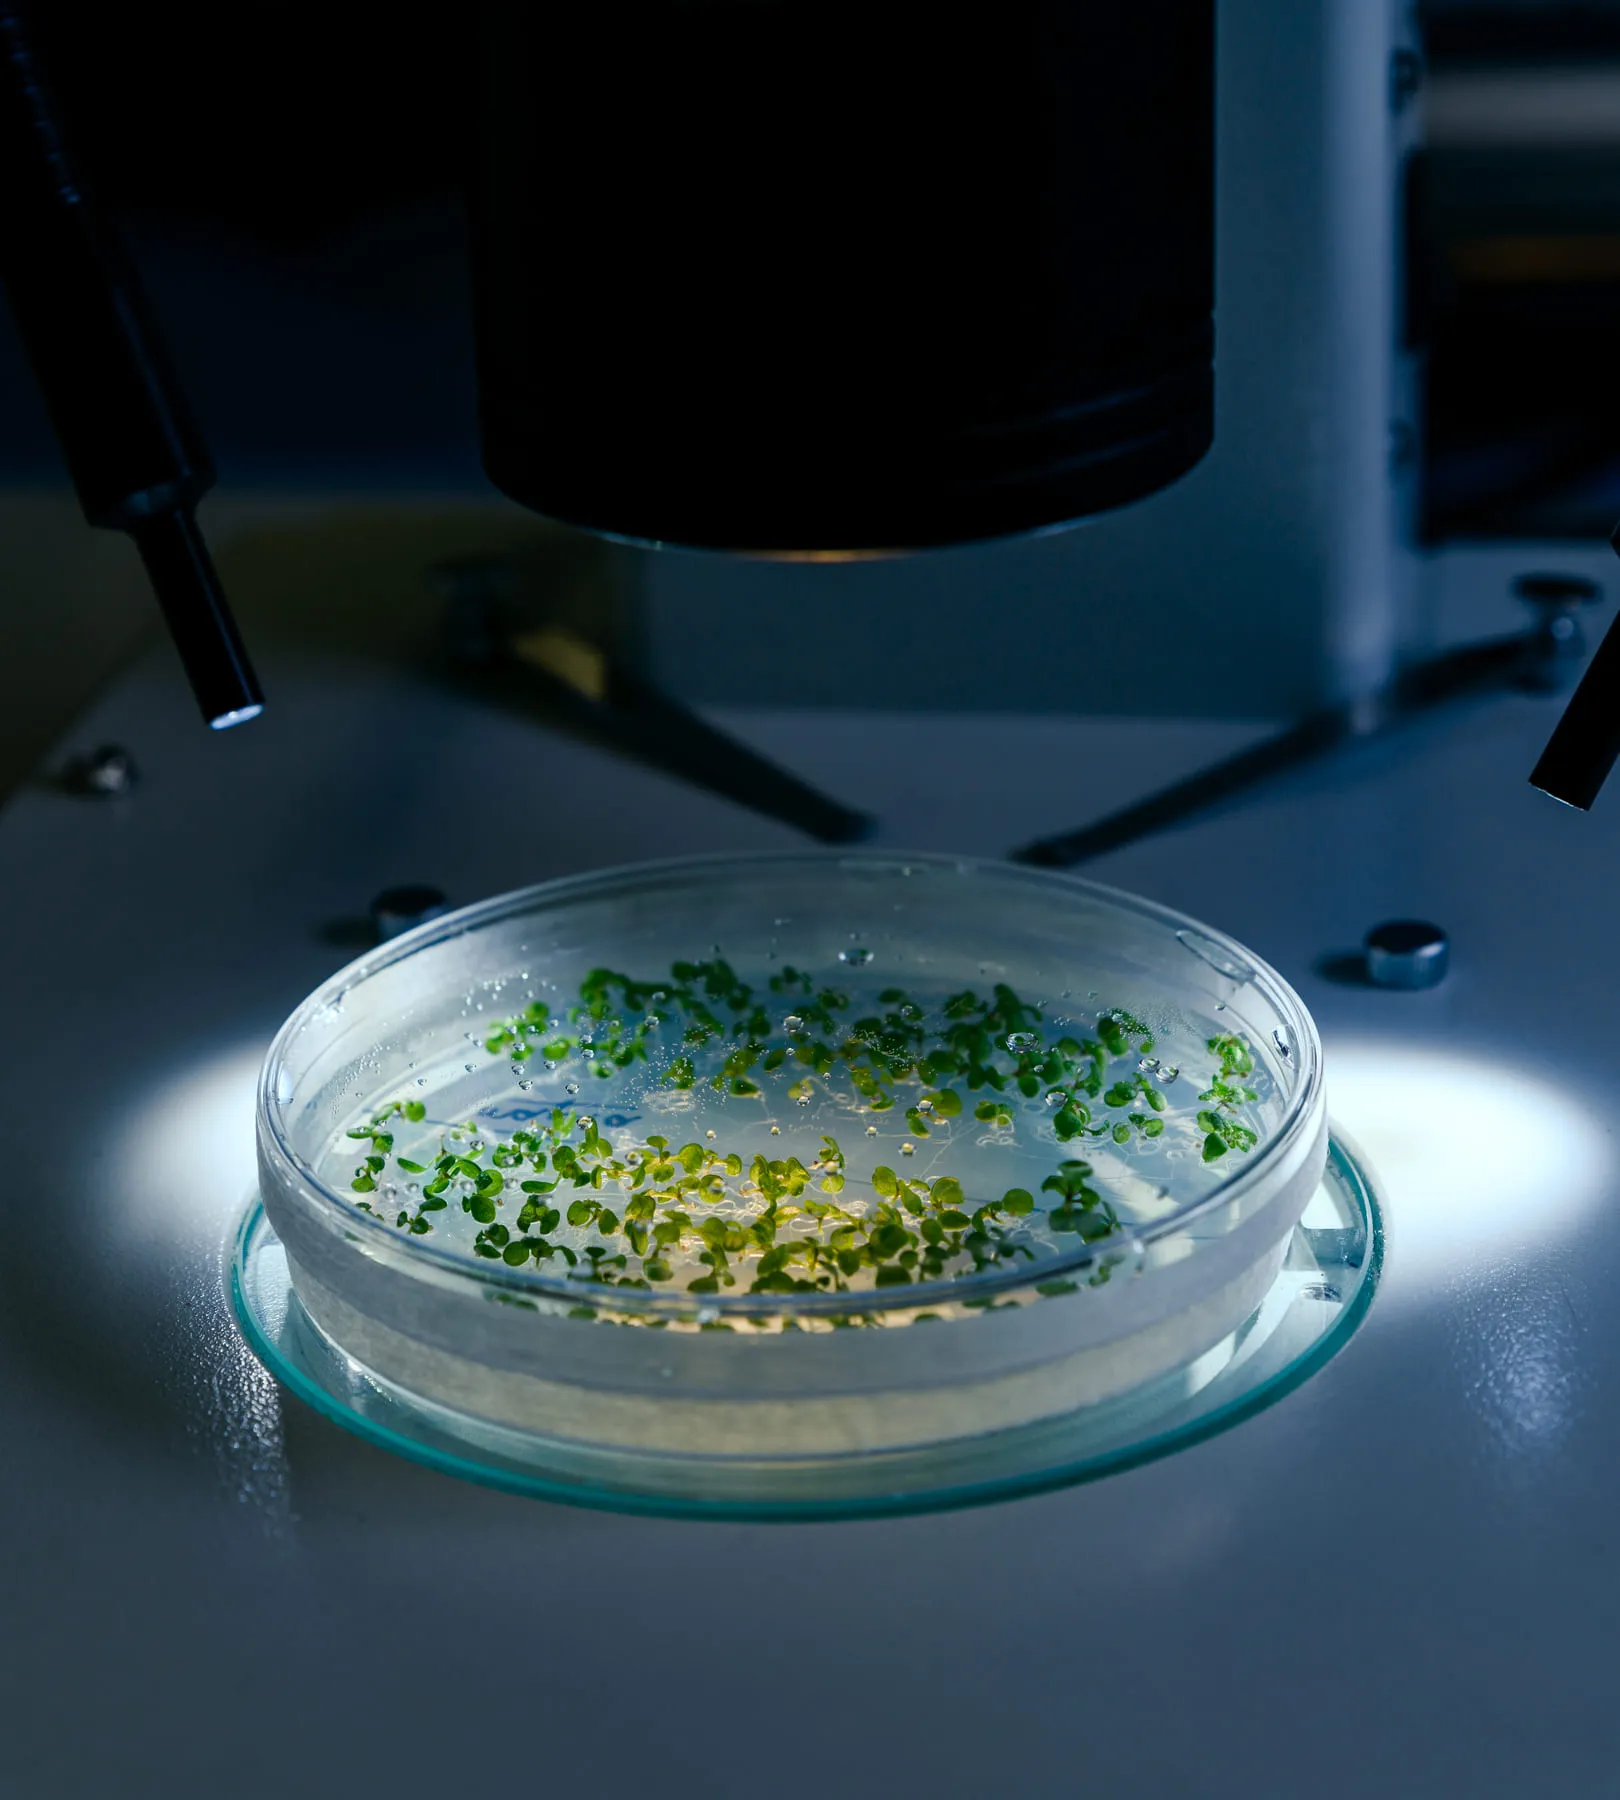

a single living material — and shape it into four distinct systems. Each serves a different world, yet all share the same origin: light, water, and algae.
From algae, light, and time — we create things that serve a purpose and then quietly disappear.
Living systems, soft tech
a biomaterial studio, working like nature. Not forging or molding — but cultivating.
The world doesn’t need another product It needs a better way of making things


Tactile
Panels, coatings, and films grown from algae.
Light-bending panels, films, and textures that breathe with the space. They shift tone through the day, age like natural stone or wood, and replace static glass with a living surface.
Each piece is grown, not made — shaped by light, water, and time, bringing the calm precision of nature into modern design
Luminous light panels
Flexible glass from agar-agar
Laminated layers for interior design




Edible
Biodegradable, edible tableware and shells.
Plates, spoons, and wrappers that disappear with the meal. Shimmering like jelly, folding like seaweed — no waste, just a beautiful ending to the dish.
Perfect for chef’s tables, artful catering, and events where the presentation lives as vividly as the flavor.
Drink and sauce capsules (agar)
Plates that dissolve after use
Spoons from kelp




Remedy
Medical and wellness forms made with algae.
Cooling gels, healing patches, nutrient capsules — all born from algae, all designed to restore. Gentle to the body, kind to the planet, gone without a trace.
Every form is a meeting point of biotechnology and care — made to heal faster, travel lighter, and leave nothing behind.
Cooling algae gel
Biodegradable healing patch
Nutrient capsules with smart algae shells




Living
Living systems that clean air, shape facades, and grow food.
Walls that clean air, panels that respond to sunlight, compact ecosystems for homes and cities. Algae at work — breathing, filtering, giving life back to the space.
A quiet technology for a louder future — turning buildings into gardens and rooms into tiny self-sustaining worlds.
Facade biopanels
Tabletop air purifier with live algae
Modular air-cleansing units for homes



Algae have been here long before us—And they’ll be here long after
chefs, architects, researchers, artists, and labs.
Together, we invent bio-based solutions for a world that can’t afford more waste.

Growth becomes harmony when it’s shared creating a future alive with possibility
How are your materials different from traditional ones?
Can your materials be customized?
Are they safe for people and the environment?
What makes your materials sustainable?
How long do they last?
How do light, water, and algae work together?
Do your systems replace traditional ventilation or climate control?